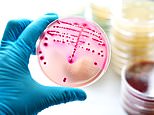

Superbugs pose a grave threat to Britain’s cancer patients, experts fear
Superbugs pose a grave threat to Britain’s cancer patients and could kill more people than Covid-19, experts fear
By John Naish for the Daily Mail
Published: 18:06 EDT, 6 July 2020 | Updated: 18:06 EDT, 6 July 2020
We are in the middle of a coronavirus pandemic, yet some of Britain’s leading infection experts are quietly asking an astonishing question: are we forgetting about a bigger threat to humankind?
This threat comes from bacteria that are collaboratively learning to resist our most powerful drugs, putting our health — and lives — at risk.
The toll is dramatic. As many as 2,985 people in England died from antibiotic-resistant infections in 2018; and 60,788 patients were infected — a rise of nearly ten per cent over the previous year.
![This threat comes from bacteria that are collaboratively learning to resist our most powerful drugs, putting our health — and lives — at risk [File photo]](https://i.dailymail.co.uk/1s/2020/07/06/21/30459114-8495545-image-a-1_1594068292876.jpg)
![This threat comes from bacteria that are collaboratively learning to resist our most powerful drugs, putting our health — and lives — at risk [File photo]](https://i.dailymail.co.uk/1s/2020/07/06/21/30459114-8495545-image-a-1_1594068292876.jpg)
This threat comes from bacteria that are collaboratively learning to resist our most powerful drugs, putting our health — and lives — at risk [File photo]
Last year, the total number of infections leapt again, to 90,173, according to figures released by NHS Digital. These indicate that antibiotic-resistant cases in England have risen by almost a third in the past four years.
The numbers are part of a global pandemic. In the U.S., more than 2.8 million people have an antibiotic-resistant infection diagnosed every year, and 35,000 die.
So alarming is the rise of antibiotic-resistant superbugs, experts warn that we have to prepare for a time when common ailments such as strep throat, urinary tract infections and food poisoning become untreatable.
And NHS cancer experts have expressed their fear that chemotherapy soon won’t be an option for patients as it may render them too vulnerable to such infections.
Any lethal infectious outbreak is devastating, as we know with coronavirus. It has killed more than 44,000 in the UK and over 530,000 worldwide since December. But some experts fear coronavirus is distracting us from the dangers of antibiotic resistance.
Timothy Walsh, a professor of medical microbiology at Cardiff University, who recently received an OBE for his work on antibiotic resistance, told Good Health: ‘Antibiotic resistance, by most estimates, is killing 800,000 people a year worldwide. By 2050, it will kill ten million people annually.
‘With the current global efforts and funding, by 2021 there may be a vaccine for Covid-19 and, within 18 months, it will probably be over. I would hate to see it taking funding away from the fight against antibiotic resistance that is a longer-term problem for us all.’
Professor Walsh believes differing public responses to coronavirus (i.e. alarm) and antibiotic-resistant bacteria (relatively complacent) are because coronavirus appeared with speed, while superbugs are ‘slow-burn’.
Lord O’Neill, chair of the Chatham House think-tank, who led a British government global review of antibiotic resistance in 2016, tells Good Health: ‘I think the difference in responses reflects one of the huge societal challenges in life. Something that is not in the headlines every night does not result in dramatic action.’
Inappropriate use of antibiotics is commonly blamed for the rise of resistant bacteria. Last year, a report in the Journal of Global Infectious Diseases cited over-prescribing and overuse in agriculture, along with poor-quality antibiotics in the developing world — which don’t kill bacteria — and drugs sold without prescription.
While global efforts to cut anti-biotic use are being made, they threaten to be too little, too late.
Doctors now fear antibiotic-resistant bacteria may shut down chemotherapy for cancer patients. In February, a survey of 100 NHS oncologists found nearly half fear superbugs will render it unviable.
This is because patients’ immune systems become weakened during treatment so antibiotics are needed because patients cannot fend off bacterial infections without them.
But the rise of superbugs means chemotherapy may become too perilous as it would mean exposing vulnerable patients to an unacceptably high risk of being colonised by lethal bacteria.
![Doctors now fear antibiotic-resistant bacteria may shut down chemotherapy for cancer patients. In February, a survey of 100 NHS oncologists found nearly half fear superbugs will render it unviable [File photo]](https://i.dailymail.co.uk/1s/2020/07/06/21/30460264-8495545-image-a-3_1594068491255.jpg)
![Doctors now fear antibiotic-resistant bacteria may shut down chemotherapy for cancer patients. In February, a survey of 100 NHS oncologists found nearly half fear superbugs will render it unviable [File photo]](https://i.dailymail.co.uk/1s/2020/07/06/21/30460264-8495545-image-a-3_1594068491255.jpg)
Doctors now fear antibiotic-resistant bacteria may shut down chemotherapy for cancer patients. In February, a survey of 100 NHS oncologists found nearly half fear superbugs will render it unviable [File photo]
The oncologists reported that already about one in 20 of their patients has contracted an infection that did not respond to antibiotics.
They cited the bacteria Staphylococcus, E. coli and Pseudomonas as the most serious infectious threats (which can cause chronic treatment-resistant infections throughout the body).
What particularly concerns Professor Walsh is the rapid global spread of two bacterial genes, called MCR-1 and NDM-1, which give bacteria the power to resist some of our strongest antibiotics, such as colistin.
The MCR-1 gene was first reported in China in 2015 in humans and pigs with E. coli infections. The antibiotic was being routinely given to chickens and pigs in animal feed.
Investigators believe this encouraged genetic resistance to flourish inside the animals, then infect people who ate their flesh. Less than six months later, the MCR-1 gene turned up in bacteria cultured from a patient in Pennsylvania. Her urinary tract was infected with antibiotic-resistant E. coli. How she caught it remains a mystery. She had not travelled abroad, nor worked with animals.
MCR-1 has since been found in Salmonella, Klebsiella and different types of enterobacter bacteria, all of which cause infections in humans. In February, a Wyoming patient with a urinary tract infection was found to have a strain of Klebsiella that had acquired the MCR-1 gene and become resistant to 16 antibiotics.
A similar problem is arising with the gene NDM-1, which enables bacteria to beat a crucial class of antibiotics called carbapenems. It was first identified in a Swedish patient who had caught a Klebsiella pneumoniae urinary tract infection in India in 2008.
Now NDM-1 has moved into other strains of bacteria, such as E. coli. It is found in scores of countries including the UK, U.S. and Australia. Bacteria will grow on any surface in the ocean, which is one way it may be spread around the world, warns a study in the journal Marine Pollution Bulletin.
Filling the ocean with plastics creates billions of new habitats. Worse still, these plastics may be swallowed by fish and thus enter the human food chain. This would increase the spread of antibiotic-beating infections.
We could be moving towards a world in which sore throats may turn fatal. In January, infectious disease scientists reported in the Journal of Clinical Microbiology how strains of group A Streptococcus are becoming increasingly resistant to antibiotics.
The bacteria cause up to a third of sore throats in children and one in six in adults. Researchers warn that strep throat and necrotising fasciitis (or flesh-eating disease), both caused by Strep A bacteria, may be moving closer to acquiring full resistance to penicillin and beta-lactam antibiotics.
‘If this germ becomes truly resistant to these antibiotics, it would have a very serious impact on millions of children,’ says James Musser, a professor of genomic medicine at Weill Cornell Medical College in the U.S., who led the study.
Another study, published in February, warns that Bordetella pertussis, the bacteria that cause whooping cough, are also becoming resistant to antibiotics. The contagious disease can prove fatal to newborns and young children.
Dr Laurence Luu, a micro- biologist at the University of New South Wales, Australia, who led the study, published in the journal Vaccine, says the bacteria are also evolving new genetic mutations that make them faster and more efficient at infecting hosts.
And some strains are altering their make-up so much, they can even infect people inoculated against whooping cough because antibodies created by the vaccine don’t recognise them.
In March, European Union data flagged another fast-emerging threat: food-poisoning bacteria are also increasingly evolving into resistant superbugs.
Analysis of strains of Salmonella and Campylobacter taken from sick patients shows nearly a third of infections are resistant to several antibiotics, including important drug ciprofloxacin.
One obvious response to the problem is to develop new, more effective antibiotics. But no new antibiotics have been developed since the Eighties, and none seem to be on the horizon.
Lord O’Neill warns: ‘Big Pharma does not seem excited by the prospect of developing new antibiotics, which is troubling.’
Professor Walsh says public funding is needed to ensure new drugs save lives.
‘We need an injection of money and to make drugs affordable and available to lower-income countries,’ he says.
![Bacteria will grow on any surface in the ocean, which is one way it may be spread around the world, warns a study in the journal Marine Pollution Bulletin. Filling the ocean with plastics creates billions of new habitats [File photo]](https://i.dailymail.co.uk/1s/2020/07/06/21/30460308-8495545-image-a-4_1594068592916.jpg)
![Bacteria will grow on any surface in the ocean, which is one way it may be spread around the world, warns a study in the journal Marine Pollution Bulletin. Filling the ocean with plastics creates billions of new habitats [File photo]](https://i.dailymail.co.uk/1s/2020/07/06/21/30460308-8495545-image-a-4_1594068592916.jpg)
Bacteria will grow on any surface in the ocean, which is one way it may be spread around the world, warns a study in the journal Marine Pollution Bulletin. Filling the ocean with plastics creates billions of new habitats [File photo]
Secrets of an A-list body: How to get the enviable physiques of the stars
This week: Celine Dion’s toned waist.
Celine Dion sparkled on stage in a tight, red dress earlier this year, that showed off her toned waistline.
The French-Canadian singer credits ballet training with transforming her physique since discovering it last year.
The mother-of-three, 52, often works out with one of her dancers, Pepe, and has said: ‘We stretch and we do the barre. I do this four times a week.’
What to try: The quadruped hip extension firms the waist. Start on all fours with knees and feet hip-width apart and hands under shoulders.
Tighten your abdominal muscles. Lift your left leg, pressing the foot towards the ceiling. Lower your leg back to the start position, repeat, then change sides.
Perform 12 repetitions each side and two to three sets.


Celine Dion sparkled on stage in a tight, red dress earlier this year, that showed off her toned waistline
![]()